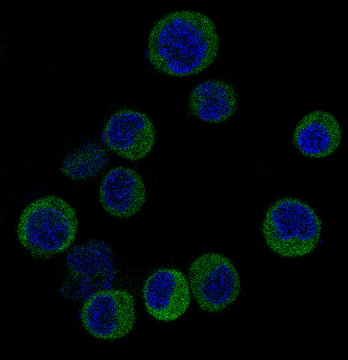

-
分类: 科研抗体货号: P22826别名: hAGP7; Ubiquitin-activating enzyme E1-like protein; APG7L应用: WB,IP,IHC,IF,FCM反应种属: Human
-
分类: 科研抗体货号: P22851别名: ADP-ribosylation factor 1应用: WB,IHC,FCM反应种属: Human,Mouse,Rat
-
分类: 科研抗体货号: P22825别名: RDX; Radixin应用: WB,IP,IHC,IF,FCM反应种属: Human,Mouse,Rat
-
分类: 科研抗体货号: P22866别名: HDAC8; HDACL1; CDA07; Histone deacetylase 8; HD8应用: WB,IP,FCM反应种属: Human,Mouse,Rat
-
分类: 科研抗体货号: P22850别名: IL-1 Receptor Antagonist Protein; DIRA; IRAP; IL1F3; IL1RA; MVCD4; IL-1RN; IL-1ra; IL-1ra3; ICIL-1RA应用: WB,IP,IHC,IF,FCM反应种属: Human,Mouse,Rat
-
分类: 科研抗体货号: P22865别名: TF6; HMSNP; SPG57; TRKT3应用: WB,IP,IHC,IF反应种属: Human,Mouse,Rat
-
分类: 科研抗体货号: P22849别名: GYS1; GYS; Glycogen [starch] synthase; muscle应用: WB,IP,IHC,IF,FCM反应种属: Human,Mouse,Rat
-
分类: 科研抗体货号: P22864别名: Transcription factor jun-B应用: WB,IP,IF反应种属: Human,Mouse,Rat
-
分类: 科研抗体货号: P22848别名: IRF3; Interferon regulatory factor 3; IRF-3应用: WB,IHC,IF,FCM反应种属: Human,Mouse,Rat
-
分类: 科研抗体货号: P22863别名: FOXO4; AFX; AFX1; MLLT7; Forkhead box protein O4; Fork head domain transcription factor AFX1应用: WB,IP,IF,FCM反应种属: Human,Mouse,Rat

鄂公网安备42018502007531号
鄂公网安备42018502007531号

